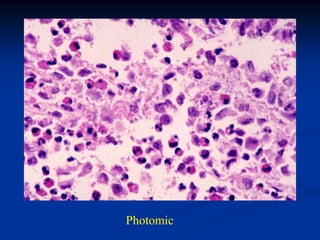
Photomic

The document discusses eosinophilic granuloma, a benign histiocytic disorder most commonly seen in children ages 5-15. It often presents as inflammatory bone pain and can resemble conditions like Ewing's sarcoma on x-ray with its permeative, onion-skin appearance. Microscopically, biopsies show large pale histiocytes speckled with eosinophils. Treatment involves surgical curettage or resection for symptomatic relief with a good prognosis.